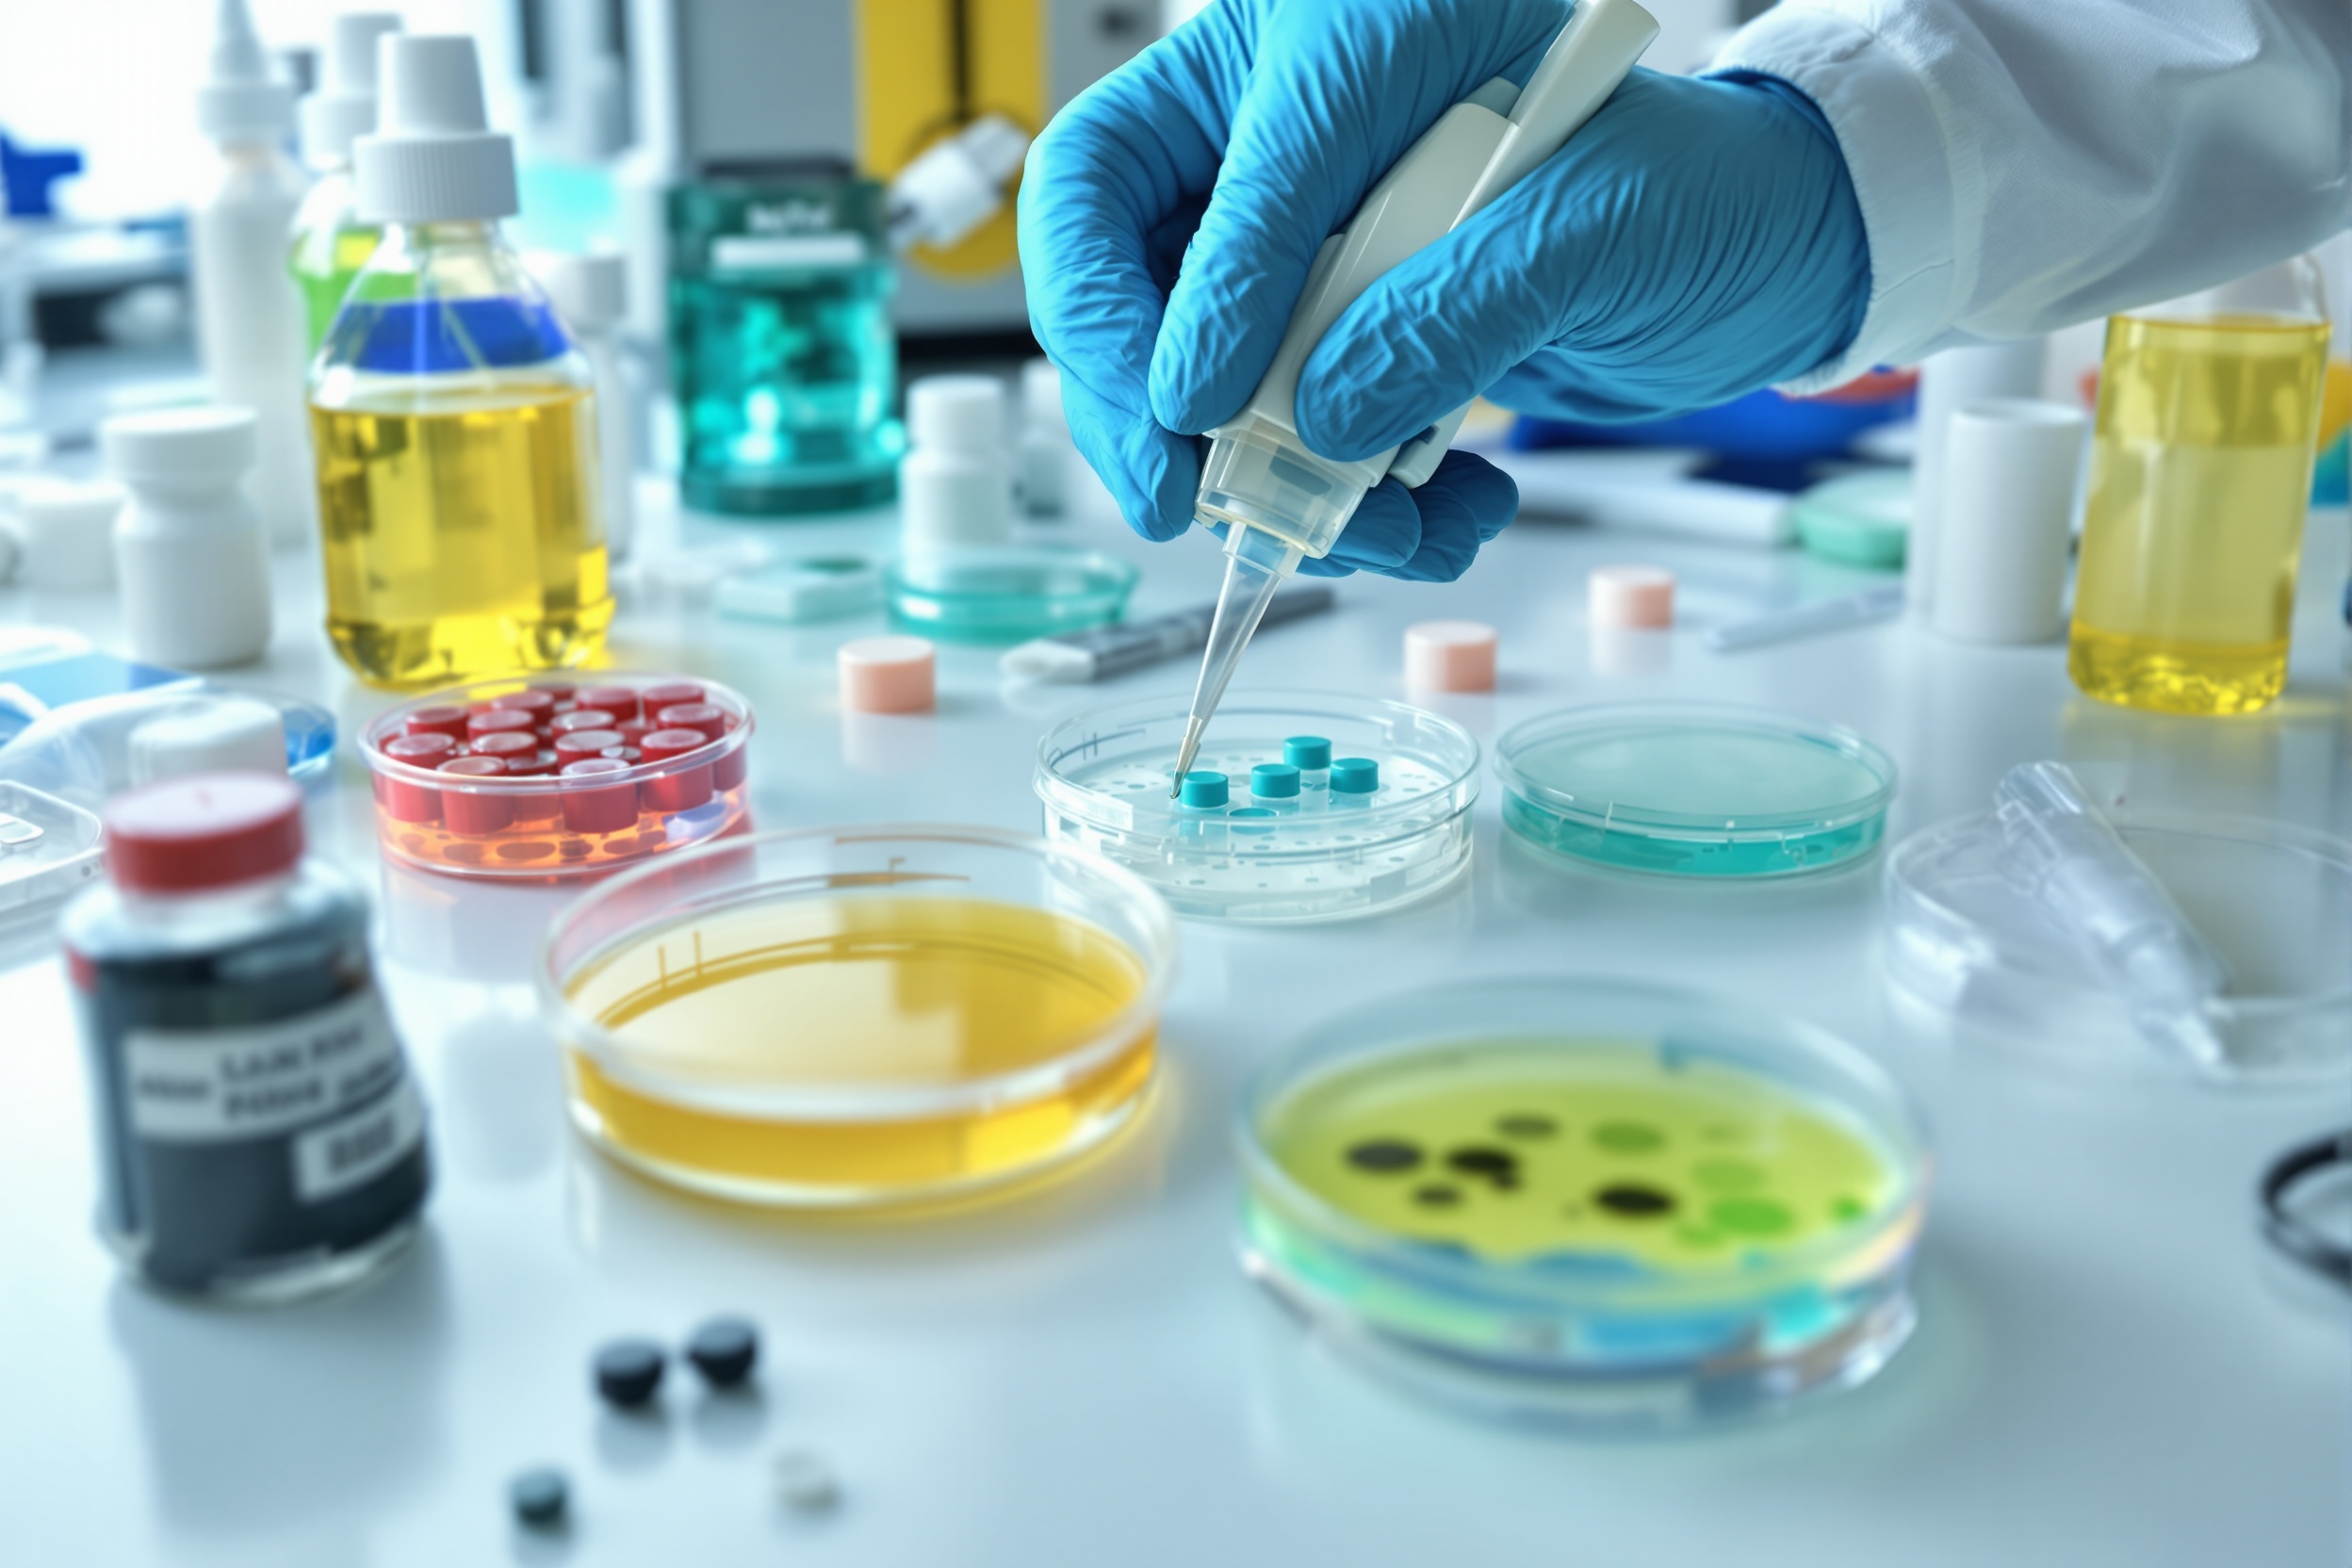
Mold Testing

Comprehensive mold testing and inspection services backed by state licensing and years of expertise
Comprehensive mold testing using state-of-the-art equipment and laboratory analysis to identify mold species and concentration levels in your property.
Thorough visual inspection and moisture mapping to detect hidden mold growth, identify moisture sources, and assess the extent of contamination.
State-licensed comprehensive reports with findings, lab results, photographic evidence, and professional recommendations for remediation.
Expert consultation on mold prevention, remediation strategies, and health safety protocols to protect your property and occupants.
Pre-purchase and pre-sale mold inspections for real estate transactions, providing peace of mind for buyers and sellers.
Round-the-clock emergency mold inspection services for urgent situations including water damage, flooding, and health concerns.
Mold can develop in many places — knowing where to look is the first step to protecting your property.
Mold can accumulate on coils, filters, and ducts, distributing spores throughout the building.
Constant moisture, poor ventilation, and hidden plumbing leaks create ideal mold growth zones.
Often dark and damp, these areas need moisture barriers and regular monitoring.
Roof leaks or poor ventilation can result in hidden attic mold that spreads undetected.
Unseen leaks from pipes or appliances can cause mold to thrive unnoticed for months.
Our inspectors will assess every area of your property and give you a clear, certified report.